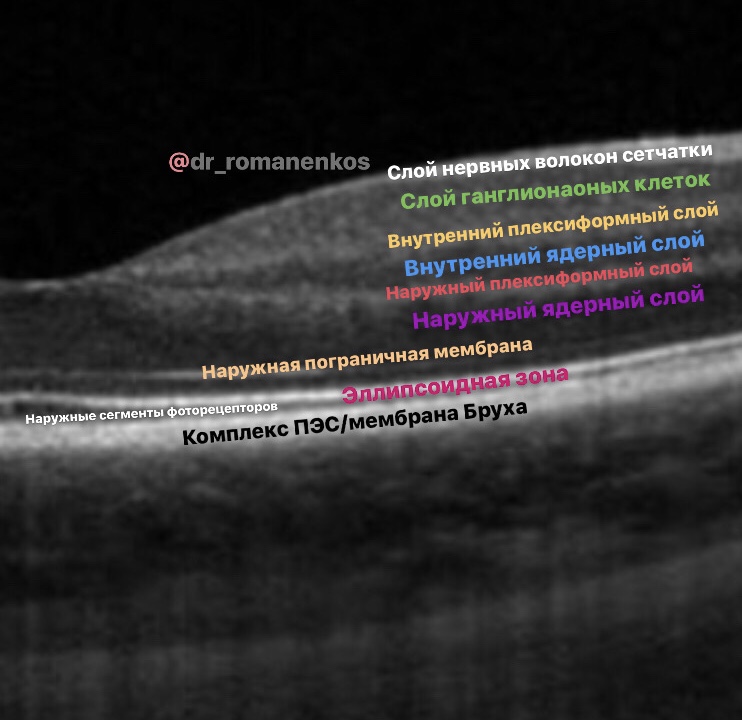

Авторский проект доктора Романенко
Первая тренировочная онлайн-платформа
Здесь мы настраиваем клиническое мышление!

...более 2700 докторов уже прошли обучение...
Тренинги:
ОКТ.НАЧАЛО
ОКТ.ДИСТРОФИИ
ОКТ.ОТЕКИ
ОКТ и ОКТ-ангиография
Анти-VEGF терапия в томографиях
Идущие по нарастающей практических знаний и сложности случаев...
Можно по одному, можно все сразу.
ОКТ.НАЧАЛО
ОКТ.ДИСТРОФИИ
ОКТ.ОТЕКИ
ОКТ и ОКТ-ангиография
Анти-VEGF терапия в томографиях
Идущие по нарастающей практических знаний и сложности случаев...
Можно по одному, можно все сразу.
Только для офтальмологов
Доступные тренинги
С этих знаний стоит начинать разговор об ОКТ!
Нам необходимо четкое умение определять анатомические ориентиры, узнавать структуры на ОКТ и видеть патологические изменения - и у НАС оно появится:
1. Мы начнем с основ и принципов самой технологии;
2. Разберем типы сканирования ОКТ, научимся давать качественную и количественную оценку снимкам;
3. В стиле @dr_romanenkos проработаем ОКТ-АНАТОМИЮ глаза;
4. Мы разберем все общие признаки патологий, которые встречаются в оптической когерентной томографии;
5. И самое главное - мы НАУЧИМСЯ ОПИСЫВАТЬ СКАНЫ ОКТ!
После регистрации Вам будет создан личный кабинет на сайте GetCourse.ru
Курс доступен в аккаунте проекта STROMASCHOOL stromaschool.getcourse.ru
Нам необходимо четкое умение определять анатомические ориентиры, узнавать структуры на ОКТ и видеть патологические изменения - и у НАС оно появится:
1. Мы начнем с основ и принципов самой технологии;
2. Разберем типы сканирования ОКТ, научимся давать качественную и количественную оценку снимкам;
3. В стиле @dr_romanenkos проработаем ОКТ-АНАТОМИЮ глаза;
4. Мы разберем все общие признаки патологий, которые встречаются в оптической когерентной томографии;
5. И самое главное - мы НАУЧИМСЯ ОПИСЫВАТЬ СКАНЫ ОКТ!
После регистрации Вам будет создан личный кабинет на сайте GetCourse.ru
Курс доступен в аккаунте проекта STROMASCHOOL stromaschool.getcourse.ru
Окончив курс "Оптическая когерентная томография.НАЧАЛО" мы обрели умение видеть признаки патологии на сканах OCT.
Настало время усложняться и углубляться!
ЭТОТ КУРС ПОСВЯЩЕН:
1. Дифференциальной диагностике заболеваний заднего отрезка глаза;
2. Умению видеть признаки стадий и активности заболеваний;
3. Умению формировать курсы лечения и прогнозировать перспективу для пациента.
После регистрации Вам будет создан личный кабинет на сайте GetCourse.ru
Курс доступен в аккаунте проекта STROMASCHOOL stromaschool.getcourse.ru
Настало время усложняться и углубляться!
ЭТОТ КУРС ПОСВЯЩЕН:
1. Дифференциальной диагностике заболеваний заднего отрезка глаза;
2. Умению видеть признаки стадий и активности заболеваний;
3. Умению формировать курсы лечения и прогнозировать перспективу для пациента.
После регистрации Вам будет создан личный кабинет на сайте GetCourse.ru
Курс доступен в аккаунте проекта STROMASCHOOL stromaschool.getcourse.ru
Это курс для специалистов, имеющих четкое представление о многообразии патологий заднего отрезка глаза и желающих научиться быстро и точно дифференцировать эти заболевания по такому, казалось бы НЕПАТОГНОМОНИЧНОМУ признаку, как ОТЕКИ СЕТЧАТКИ.
А самое главное, научиться строить план лечения конкретного пациента и давать прогноз этому лечению.
Впереди большая работа, но раз Вы здесь, коллега, Вы на правильном пути...
ВПЕРЕД!
После регистрации Вам будет создан личный кабинет на сайте GetCourse.ru
Курс доступен в аккаунте проекта STROMASCHOOL stromaschool.getcourse.ru
А самое главное, научиться строить план лечения конкретного пациента и давать прогноз этому лечению.
Впереди большая работа, но раз Вы здесь, коллега, Вы на правильном пути...
ВПЕРЕД!
После регистрации Вам будет создан личный кабинет на сайте GetCourse.ru
Курс доступен в аккаунте проекта STROMASCHOOL stromaschool.getcourse.ru
Весь этот курс, как и все предыдущие тренинги проекта STROMASCHOOL, имеют лишь одну принципиальную цель - донести до Вас, коллега, важную для офтальмологического труда информацию, привести Вас к важным практическим выводам и сделать так, чтобы даже если перед Вами нестандартная картина заболевания и Вы прежде такого не видели, Вы не на секунду не застопорились, а наоборот начали ДУМАТЬ, клинически думать, и смогли в итоге сделать диагностическое предположение и поставить диагноз.
А уж имея диагноз составить схему терапии труда не составит!
После регистрации Вам будет создан личный кабинет на сайте GetCourse.ru
Курс доступен в аккаунте проекта STROMASCHOOL stromaschool.getcourse.ru
А уж имея диагноз составить схему терапии труда не составит!
После регистрации Вам будет создан личный кабинет на сайте GetCourse.ru
Курс доступен в аккаунте проекта STROMASCHOOL stromaschool.getcourse.ru
Пришло время самого интересного. Через разбор технологии, препаратов, навыка набирать и колоть, а также коммуникации с пациентом, на сотнях сканов клинических примеров обучаемся лечить сетчатку.
После регистрации Вам будет создан личный кабинет на сайте GetCourse.ru
Курс доступен в аккаунте проекта STROMASCHOOL stromaschool.getcourse.ru
После регистрации Вам будет создан личный кабинет на сайте GetCourse.ru
Курс доступен в аккаунте проекта STROMASCHOOL stromaschool.getcourse.ru

Как проходит обучение?
ЗАДАЧА:
- научиться быстро и безошибочно диагностировать и лечить заболевания заднего отрезка.
МАТЕРИАЛЫ и МЕТОДЫ:
- уникальная система подачи информации, настроенная именно на ЗАПОМИНАНИЕ информации и ОТРАБОТКУ знаний;
- все материалы (фото фундус камеры, сканы ОКТ взяты из личной практики и разобраны для Вас лично мной) - это ЧЕСТНО! А здесь только так!
ЧТО В УРОКАХ?
- видео, сканы ОКТ с обозначениями, фото глазного с разбором на детали, аудисопровождение, текст и, конечно, ОБУЧАЩИЕ ТЕСТЫ
- каждый урок ведет к нескольким выводам, причем именно ВЕДЕТ, Вы дойдете до понимания автоматически, а ВЫВОД, до которого дошел сам, НЕ ЗАБЫВАЕТСЯ НИКОГДА!
- научиться быстро и безошибочно диагностировать и лечить заболевания заднего отрезка.
МАТЕРИАЛЫ и МЕТОДЫ:
- уникальная система подачи информации, настроенная именно на ЗАПОМИНАНИЕ информации и ОТРАБОТКУ знаний;
- все материалы (фото фундус камеры, сканы ОКТ взяты из личной практики и разобраны для Вас лично мной) - это ЧЕСТНО! А здесь только так!
ЧТО В УРОКАХ?
- видео, сканы ОКТ с обозначениями, фото глазного с разбором на детали, аудисопровождение, текст и, конечно, ОБУЧАЩИЕ ТЕСТЫ
- каждый урок ведет к нескольким выводам, причем именно ВЕДЕТ, Вы дойдете до понимания автоматически, а ВЫВОД, до которого дошел сам, НЕ ЗАБЫВАЕТСЯ НИКОГДА!





Кому подойдут тренинги?
Врачам поликлинического звена, ведь Вы обязаны уметь читать снимки ОКТ
Врачам, как начинающих заниматься ОКТ-диагностикой, так и уже опытных, для расширения «взгляда» и оттачивания мастерства
Ординаторам-офтальмологам
Врачам, не имеющих возможности поехать на обучение в другой город
Врачам, планирующим связать будущее с ретинологией
Врачам, которые понимают абсолютное требование к нашей профессии - ПОСТОЯННОЕ САМОСОВЕРШЕНСТВОВАНИЕ
Врачам, находящимся в декретном отпуске, но не желающим потерять квалификацию
Врачам которые хотят стать ЛУЧШЕ, УМНЕЕ, ДОРОЖЕ








В 2006 году с отличием окончил Екатеринбургское Суворовское военное Училище
В 2012 году окончил Уральскую Государственную Медицинскую Академию
В 2014 году окончил ординатуру по офтальмологии
С 2007 по 2013 год трудился в составе бригады Скорой медицинской помощи
С 2014 года занимаюсь лечением патологий глазного дна, лазерной хирургией, антиангиогенной терапией
9 декабря 2019 года основал платформенную систему обмена врачебным опытом без границ STROMASCHOOL
Об авторе
Романенко Степан Олегович





Обратная связь с автором проекта Романенко СО
Выберите тариф
13 100 руб.
Приобретая тренинг вы получаете доступ ко всем материалам тренинга на 60 дней
16 400 руб.
Приобретая тренинг вы получаете доступ ко всем материалам тренинга на 60 дней + удостоверение Государственного образца о повышении квалификации + 36 ЗЕТ

Content Oriented Web
Make great presentations, longreads, and landing pages, as well as photo stories, blogs, lookbooks, and all other kinds of content oriented projects.
Выберите тариф
10 000 руб.
Приобретая тренинг вы получаете доступ ко всем материалам курса на 60 дней
13 000 руб.
Приобретая тренинг вы получаете доступ ко всем материалам курса на 60 дней + удостоверение Государственного образца о повышении квалификации

Content Oriented Web
Make great presentations, longreads, and landing pages, as well as photo stories, blogs, lookbooks, and all other kinds of content oriented projects.
Выберите тариф
13 700 руб.
Приобретая тренинг вы получаете доступ ко всем материалам курса на 60 дней
16 900 руб.
Приобретая тренинг вы получаете доступ ко всем материалам курса на 60 дней + удостоверение государственного образца о повышении квалификации + 36 ЗЕТ

Content Oriented Web
Make great presentations, longreads, and landing pages, as well as photo stories, blogs, lookbooks, and all other kinds of content oriented projects.
Выберите тариф
22 500 руб.
Приобретая тренинг вы получаете доступ ко всем материалам курса на 60 дней
27 400 руб.
Приобретая тренинг вы получаете доступ ко всем материалам курса на 60 дней + удостоверение государственного образца о повышении квалификации + 144 ЗЕТ

Content Oriented Web
Make great presentations, longreads, and landing pages, as well as photo stories, blogs, lookbooks, and all other kinds of content oriented projects.
Выберите тариф
23 700 руб.
Приобретая тренинг вы получаете доступ ко всем материалам курса на 60 дней
28 000 руб.
Приобретая тренинг вы получаете доступ ко всем материалам курса на 90 дней + удостоверение государственного образца о повышении квалификации + 36 ЗЕТ

Content Oriented Web
Make great presentations, longreads, and landing pages, as well as photo stories, blogs, lookbooks, and all other kinds of content oriented projects.
Выберите тариф
36 000 руб.
Приобретая тренинг вы получаете доступ на 180 дней к тренингам: ОКТ.НАЧАЛО, ОКТ.ДИСТРОФИИ, ОКТ.ОТЕКИ
39 000 руб.
Приобретая тренинг вы получаете доступ 180 дней к тренингам: ОКТ.НАЧАЛО, ОКТ.ДИСТРОФИИ, ОКТ.ОТЕКИ + вы получаете удостоверение о повышении квалификации и 144 часа НМО - это полноценное ОКТ-обучение

Content Oriented Web
Make great presentations, longreads, and landing pages, as well as photo stories, blogs, lookbooks, and all other kinds of content oriented projects.
Выберите тариф
81 000 руб.
Приобретая тренинг вы получаете доступ на 180 дней ко всем тренингам проекта STROMASCHOOL
86 000 руб.
Приобретая тренинг вы получаете доступ 180 дней дней ко всем тренингам проекта STROMASCHOOL + вы получаете удостоверение о повышении квалификации и 144 часа НМО

Content Oriented Web
Make great presentations, longreads, and landing pages, as well as photo stories, blogs, lookbooks, and all other kinds of content oriented projects.


